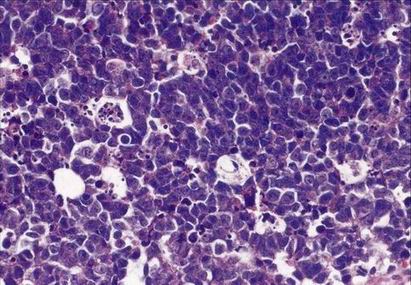
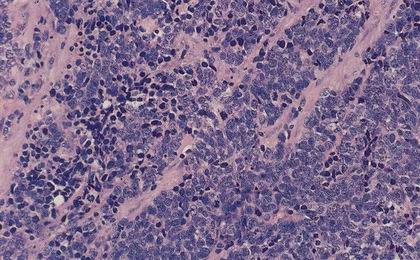

Konference: 2005 VIII. setkání Klubu mladých onkologů
Kategorie: Nádory v seniu
Téma: Konference bez tematických celků
Číslo abstraktu: 12
Autoři: MUDr. Pavel Fabián, Ph.D.
Přepis prezentace z Microsoft PowerPoint
- 90% H&N tumorů jsou spinocelulární karcinomy
- prognóza závisí především na stagingu, nikoli na histologickém typu
- což patrně vyplývá z toho, že všechny jsou spinocelulární
Histogenetická klasifikace
Epiteliální
Mesenchymální
Neuroektodermální
Lymfomy
Germinální tumory
Ostatní (např. odontogenní)
Epiteliální - benigní
Papilomy
- Schneideriánské
- dlaždicobuněčné
Adenomy
- salivary gland - like
- jiné (ceruminózní, papilární ...)
Papilomy - Schneideriánské

Papilomy - dlaždicové

Adenomy - salivary gland (like)

Pleomorphic adenoma (mixed tumor)
Basal cell adenoma
Warthin‘s tumor (cystadenolymphoma papilliferum)
Onkocytoma
Myoepithelioma
Jiné: kanalikulární, sebaceózní, intraduktální papilomy, papilární cystadenomy...
Adenomy - salivary gland like

Epiteliální - maligní - z povrchového epitelu
Spinocelulární karcinom
Sinonasální karcinom
spinocelulární (rohovějící, verrukózní, basaloidní, adenoskvamózní, vřetenobuněčný)
cylindrocelulární
adenokarcinom (intestinální, non-intestinální,low-grade papilární)
nediferencovaný
Nasopharyngeální karcinom
keratinizující
nekeratinizující (diferencovaný, nediferencovaný = lymfoepiteliom)
Neuroendokrinní karcinom
dobře difer. = karcinoid
středně difer. = atypický karcinoid
nízce difer. = malobuněčný karcinom
Spinocelulární karcinom

Verrucous carcinoma
Varianta spinoca s velmi dobrou prognózou
Definován
verukózním růstem
minimálním stupněm cytologické atypie
ostře ohraničeným růstem proti spodině (byť může infiltrovat hluboko)
Diagnózu VC z probatorní excize není možno podle uvedené definice stanovit, lze jen vyslovit suspekci.
Verrucous carcinoma

Sinonasální karcinom

Nasopharyngeální karcinom

Neuroendokrinní karcinom

Epiteliální - prekancerózy z povrchového epitelu
Dutina ústní, oropharynx, hypopharynx, larynx
Dysplázie dlaždicového epitelu
topografická variabilita normálního i dysplastického epitelu
nejsou striktní histologická kritéria
mírná, střední, těžká = (+/-) ca in situ

Limitace probatorních excizí
I jasný a velký spinocelulární karcinom může být na povrchu tvořen téměř normálním epitelem.
Zánětlivé změny napodobují dysplázii
Ve vzorku často jen epitel bez spodinového stromatu - nelze posoudit event. invazi.
„Crush“ artefakty mohou zcela znemožnit hodnocení (zvl. lymfomy a malobb. karcinomy).
Epiteliální - maligní - salivary gland like + salivary gland „true“
Low grade: acinic cell, polymorhous low-grade, basal cell, mucoepidermoid low and intermediate grade, epithelial-myoepithelial...
Intermediate grade: adenoid cystic, sebaceous, malignant myoepithelioma, lymphoepithelioma-like...
High grade: mucoepidermoid high grade, squamous, slivary duct, oncocytic, large cell undifferentiated, small cell...
Epiteliální - maligní - salivary gland


Mesenchymální - benigní
Fibrom
Haemangiom
Osteom
Chondrom
Leiomyom
Rhabdomyom
Myxom

Mesenchymální -low-grade, nejasné povahy, lokálně agresivní
Nasopharyngeální angiofibrom (testosteron-dependentní)
Chordom
Sinonasální haemangiopericytom (CAVE! odlišný od konvenčního haemangiopericytomu - nejsou nekrózy, atypie, atypické mitózy ani vysoká mitotická aktivita)
Solitární fibrózní tumor (analogický s pleurálním prototypem)
Fibromatóza (desmoid)
Obrovskobuněčný kostní tumor
Osteoblastom
Nasopharyngeální angiofibrom

Chordom

Sinonasální haemangiopericytom

Mesenchymální - maligní
Fibrosarkom
Maligní fibrózní histiocytom (MFH)
Angiosarkom + Kaposiho sarkom
Liposarkom
Osteosarkom
Chondrosarkom
Leiomyosarkom
Rhabdomyosarkom
Synoviální sarkom

Odontogenní tumory

Neuroektodermální - benigní/maligní

Lymfoproliferace

Germinální tumory
Teratomy
zralé
nezralé
Seminom/dysgerminom
Non-seminomové tumory
yolk sac tumor
chorionkarcinom
embryonální karcinom
Smíšené germinální tumory
Metastatické tumory
Histologické vyšetření může výrazně pomoci stanovit primum
spektrum cytokeratinů (CK 7 a 20),
tumor specifické markery
PSA prostata
Er, PgR mammární ca
AFP- yolc sac tumor, hepatocelulární karcinom
ttyreoglobulin - štítnice
TTF-1: štítnice a plicní nemalobuněčné karcinomy
HCG, PLAP - germinální tumory
Histologické vyšetření nemusí být vůbec přínosné
dediferencované karcinomy, zvl. karcinomy GIT
Diferenciální diagnostika malobuněčných tumorů

V klasické histologii podobné až nerozpoznatelné
K diferenciální diagnóze nezbytné imunohistochemické (IHC) vyšetření větším počtem protilátek
Bez IHC je přesná diagnóza nejistá
- 90% H&N tumorů jsou spinocelulární karcinomy
- prognóza závisí především na stagingu, nikoli na histologickém typu
- což patrně vyplývá z toho, že všechny jsou spinocelulární
Histogenetická klasifikace
Epiteliální
Mesenchymální
Neuroektodermální
Lymfomy
Germinální tumory
Ostatní (např. odontogenní)
Epiteliální - benigní
Papilomy
- Schneideriánské
- dlaždicobuněčné
Adenomy
- salivary gland - like
- jiné (ceruminózní, papilární ...)
Papilomy - Schneideriánské

Papilomy - dlaždicové

Adenomy - salivary gland (like)

Pleomorphic adenoma (mixed tumor)
Basal cell adenoma
Warthin‘s tumor (cystadenolymphoma papilliferum)
Onkocytoma
Myoepithelioma
Jiné: kanalikulární, sebaceózní, intraduktální papilomy, papilární cystadenomy...
Adenomy - salivary gland like

Epiteliální - maligní - z povrchového epitelu
Spinocelulární karcinom
Sinonasální karcinom
spinocelulární (rohovějící, verrukózní, basaloidní, adenoskvamózní, vřetenobuněčný)
cylindrocelulární
adenokarcinom (intestinální, non-intestinální,low-grade papilární)
nediferencovaný
Nasopharyngeální karcinom
keratinizující
nekeratinizující (diferencovaný, nediferencovaný = lymfoepiteliom)
Neuroendokrinní karcinom
dobře difer. = karcinoid
středně difer. = atypický karcinoid
nízce difer. = malobuněčný karcinom
Spinocelulární karcinom

Verrucous carcinoma
Varianta spinoca s velmi dobrou prognózou
Definován
verukózním růstem
minimálním stupněm cytologické atypie
ostře ohraničeným růstem proti spodině (byť může infiltrovat hluboko)
Diagnózu VC z probatorní excize není možno podle uvedené definice stanovit, lze jen vyslovit suspekci.
Verrucous carcinoma

Sinonasální karcinom
Nasopharyngeální karcinom

Neuroendokrinní karcinom
Epiteliální - prekancerózy z povrchového epitelu
Dutina ústní, oropharynx, hypopharynx, larynx
Dysplázie dlaždicového epitelu
topografická variabilita normálního i dysplastického epitelu
nejsou striktní histologická kritéria
mírná, střední, těžká = (+/-) ca in situ

Limitace probatorních excizí
I jasný a velký spinocelulární karcinom může být na povrchu tvořen téměř normálním epitelem.
Zánětlivé změny napodobují dysplázii
Ve vzorku často jen epitel bez spodinového stromatu - nelze posoudit event. invazi.
„Crush“ artefakty mohou zcela znemožnit hodnocení (zvl. lymfomy a malobb. karcinomy).
Epiteliální - maligní - salivary gland like + salivary gland „true“
Low grade: acinic cell, polymorhous low-grade, basal cell, mucoepidermoid low and intermediate grade, epithelial-myoepithelial...
Intermediate grade: adenoid cystic, sebaceous, malignant myoepithelioma, lymphoepithelioma-like...
High grade: mucoepidermoid high grade, squamous, slivary duct, oncocytic, large cell undifferentiated, small cell...
Epiteliální - maligní - salivary gland


Mesenchymální - benigní
Fibrom
Haemangiom
Osteom
Chondrom
Leiomyom
Rhabdomyom
Myxom

Mesenchymální -low-grade, nejasné povahy, lokálně agresivní
Nasopharyngeální angiofibrom (testosteron-dependentní)
Chordom
Sinonasální haemangiopericytom (CAVE! odlišný od konvenčního haemangiopericytomu - nejsou nekrózy, atypie, atypické mitózy ani vysoká mitotická aktivita)
Solitární fibrózní tumor (analogický s pleurálním prototypem)
Fibromatóza (desmoid)
Obrovskobuněčný kostní tumor
Osteoblastom
Nasopharyngeální angiofibrom

Chordom

Sinonasální haemangiopericytom

Mesenchymální - maligní
Fibrosarkom
Maligní fibrózní histiocytom (MFH)
Angiosarkom + Kaposiho sarkom
Liposarkom
Osteosarkom
Chondrosarkom
Leiomyosarkom
Rhabdomyosarkom
Synoviální sarkom

Odontogenní tumory

Neuroektodermální - benigní/maligní

Lymfoproliferace

Germinální tumory
Teratomy
zralé
nezralé
Seminom/dysgerminom
Non-seminomové tumory
yolk sac tumor
chorionkarcinom
embryonální karcinom
Smíšené germinální tumory
Metastatické tumory
Histologické vyšetření může výrazně pomoci stanovit primum
spektrum cytokeratinů (CK 7 a 20),
tumor specifické markery
PSA prostata
Er, PgR mammární ca
AFP- yolc sac tumor, hepatocelulární karcinom
ttyreoglobulin - štítnice
TTF-1: štítnice a plicní nemalobuněčné karcinomy
HCG, PLAP - germinální tumory
Histologické vyšetření nemusí být vůbec přínosné
dediferencované karcinomy, zvl. karcinomy GIT
Diferenciální diagnostika malobuněčných tumorů

V klasické histologii podobné až nerozpoznatelné
K diferenciální diagnóze nezbytné imunohistochemické (IHC) vyšetření větším počtem protilátek
Bez IHC je přesná diagnóza nejistá
Datum přednesení příspěvku: 4. 6. 2005
